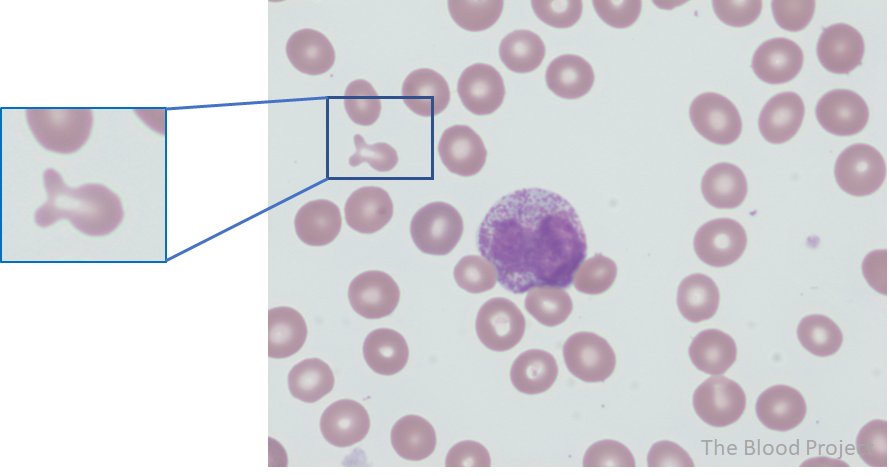

| Red blood cell, shape abnormality | Fish-shaped red cell |
| Also known as | Mushroom-shaped cell |
| Definition | Similar to tear-drop cells, fish-shaped cells have one round and one tapered end. In contrast to teardrop cells, the tapered end flares out into two buds, causing the appearance of fish’s tail. |
| Conditions associated with the shape abnormality | Not observed in peripheral blood smears of healthy persons; found in hereditary elliptocytosis, iron deficiency anemia, lymphoproliferative disorders and myelofibrosis. The number of fish-shaped red cells on a smear has been significantly associated with severity of anemia. |
| Mechanism of formation | Unknown |
| Source/author | William Aird |
| Reviewed and edited by | Parul Bhargava |
| References | Clin Chem Lab Med. 2018;56:323 |